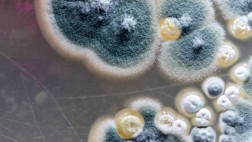

|
Xalapa.-
Celebra Orquesta Municipal su 32 aniversario |
| 2023-04-14 22:09:01 |
 |

|
Estatal.-
Tácitamente, acepta Cuitláhuac precampaña de corcholatas en Veracruz: 'se vive ya en un ambiente político' dice |
| 2023-04-14 21:28:43 |
 |

|
Estatal.-
Monreal asegura ser el más preparado para la Presidencia y anuncia que va por derogación del delito contra las instituciones de Seguridad en Veracruz |
| 2023-04-14 21:18:53 |
 |

|
Estatal.-
Quedó demostrado que violaron mis derechos y el debido proceso; Gobierno de Veracruz no acató recomendaciones de CNDH: del Río Virgen |
| 2023-04-14 21:17:27 |
 |

|
Estatal.-
Destacan a Adhara Pérez, niña genio de Boca del Río, quien aparece en portada de revista Marie Claire |
| 2023-04-14 21:16:20 |
 |

|
Estatal.-
Productos del campo veracruzano valen 10 veces más en el extranjero, afirma titular de Sedecop |
| 2023-04-14 21:14:00 |
 |

|
Estatal.-
Critican en redes a oficial mayor de la SEV por gastar dinero en promocionarse con miras a un cargo de elección popular |
| 2023-04-14 21:12:54 |
 |

|
Tuxpan.-
Primer gran Papaqui del Carnaval Tuxpan 2023 |
| 2023-04-14 20:46:28 |
 |

|
Xalapa.-
Aprueba Consejo de Desarrollo Municipal informes de obra pública |
| 2023-04-14 20:16:43 |
 |

|
Xalapa.-
Ayuntamiento, en favor de la protección de áreas naturales |
| * Convenio interinstitucional plantea la conservación del Parque Lineal Quetzalapan-Sedeño
2023-04-14 20:06:27 |
 |
|
Efemerides.-
15 de abril |
| 1911.- Tropas norteamericanas cruzan en México el Río Grande y combaten contra los insurgentes.
2023-04-14 19:54:54 |
 |
|
Mundo.-
Alerta por el brote de hongos más grande en la historia: muere la primera persona tras infectarse |
| Hay otros 100 casos sospechosos y 12 personas hospitalizadas
2023-04-14 19:51:37 |
 |

|
Nacional.-
Clima México hoy 15 de abril de 2023, se espera frío y lluvias |
| El SMN presentó el pronóstico del clima México para hoy 15 de abril de 2023, el cual prevé la entrada de un nuevo frente frío y lluvias en el noreste, orien... 2023-04-14 19:44:59 |
 |

|
Nacional.-
Se estudiarán alternativas para el INAI: Monreal |
| El senador Ricardo Monreal aseguró que hay tres alternativas para solucionar el tema de la falta de comisionados del Instituto Nacional de Acceso a la Infor... 2023-04-14 19:41:05 |
 |

|
Tecnología.-
Autorizan a SpaceX lanzar cohete Starship al espacio |
| 2023-04-14 19:28:44 |
 |

|
Deportes.-
Honduras, Haití y Qatar, rivales de México en Copa Oro 2023 |
| 2023-04-14 19:25:30 |
 |

|
Finanzas.-
Mercados mexicanos cierran con pérdidas la sesión del viernes |
| 2023-04-14 19:22:45 |
 |

|
Nacional.-
Niña de 4 años es encontrada muerta y semienterrada en Guasave, Sinaloa; mamá no sabe español y será acusada de feminicidio |
| Una mujer tarahumara es detenida por presuntamente matar y semienterrar a su propia hija de solo 4 años.
2023-04-14 19:18:08 |
 |

|
Nacional.-
¿Qué pasó en la Línea 12 del Metro CDMX? Se cae estructura metálica en las obras de reconstrucción; no hay heridos |
| Reportan la caída de una estructura metálica en las obras de la Línea 12 del Metro CDMX; no hay heridos
2023-04-14 19:15:55 |
 |

|
Nacional.-
AMLO promete que se va a terminar el problema de las desapariciones, en Zacatecas |
| La palabra de AMLO ahora va para Zacatecas: el presidente promete que el problema de desapariciones en la entidad se va a terminar
2023-04-14 19:10:16 |
 |

|
Nacional.-
Protestan contra el regreso de Lorenzo Córdova a la UNAM |
| En la UNAM protestan por el regreso de Lorenzo Córdova como investigador en la institución
2023-04-14 19:07:55 |
 |

|
Tuxpan.-
Cabildo de Tuxpan aprueba donación de predios para escuelas |
| 2023-04-14 17:52:41 |
 |

|
Mundo.-
'Arde Francia': los violentos disturbios por la aprobación de la reforma de pensiones |
| El Consejo Constitucional francés validó el retraso de la edad mínima de jubilación de 62 a 64 años
2023-04-14 17:24:43 |
 |

|
Policiaca.-
Encuentran el cadáver de una mujer en el rancho donde buscaban a Bionce Amaya |
| De acuerdo con autoridades de Nuevo León, la propiedad es de familiares de la joven desaparecida
2023-04-14 17:21:50 |
 |

|
Policiaca.-
Jacqueline desapareció el Viernes Santo: su cuerpo fue encontrado en una finca abandonada |
| Familiares y amigos buscaron a la joven por varios días, estaba en el Semefo en calidad de desconocida
2023-04-14 17:20:16 |
 |

|
Policiaca.-
Detienen a una banda de extorsionadores en Tlalpan: cuatro eran policías |
| Ocho personas que se dedicaban al delito de extorsión al sur de la ciudad fueron detenidas en un operativo
2023-04-14 17:18:04 |
 |

|
Nacional.-
'¿Dónde están nuestros hijos?': increpan a AMLO en Zacatecas, hasta arrojan una piedra a su camioneta |
| López Obrador afirmó que se mantendrá el apoyo al gobernador David Monreal
2023-04-14 17:15:00 |
 |

|
Mundo.-
'La DEA no se detendrá': EU anuncia que va con todo contra los hijos del 'Chapo' Guzmán por el fentanilo |
| Quieren interrumpir el flujo de fentanilo ilegal y otras drogas peligrosas vendidas por el Cártel de Sinaloa
2023-04-14 17:12:52 |
 |

|
Espectáculos .-
Drake Bell amenazó con suicidarse tras pelearse con su esposa |
| Un medio estadunidense filtró una llamada al 911 donde se informa que Drake Bell amenazó con quitarse la vida.
2023-04-14 17:05:51 |
 |

|
Nacional.-
FGR cita a 4 funcionarios que mutilaron rayas en Sonora |
| Las rayas fueron mutiladas para retirarles el aguijón y evitar que picaran a los turistas.
2023-04-14 17:00:16 |
 |

|
Tecnología.-
Dan 'tratamiento de belleza' a imagen de agujero negro con inteligencia artificial |
| 2023-04-14 16:55:58 |
 |

|
Nacional.-
Sin transparencia la democracia no es viable: Inai |
| 2023-04-14 16:53:38 |
 |

|
Mundo.-
Vladimir Putin promulga ley que perseguirá a rusos que no quieran servir en el ejército |
| En el marco de la guerra entre Rusia y Ucrania, Vladimir Putin promulgó una ley para perseguir rusos que se niegues a servir al Ejército
2023-04-14 16:48:32 |
 |

|
Estatal.-
¿Qué pasó en Veracruz? Balacera y persecución en bulevar Manuel Ávila Camacho de Boca del Río deja un muerto |
| Ricardo Monreal se encontraba a pocos kilometros de donde ocurrió la balacera: aún no hay detenidos por estos hechos.
2023-04-14 16:46:32 |
 |

|
Nacional.-
¿Gracias, Yasmín Esquivel? UNAM ya puede anular títulos por plagio y otras prácticas deshonestas |
| A partir de este viernes 14 de abril, entraron en vigor los cambios a las normas y reglamentaciones de la UNAM con los que se permite la anulación de título... 2023-04-14 16:44:37 |
 |

|
Nacional.-
Defensa de Lozoya pide a UIF respuesta sobre fecha para convenio |
| La defensa legal de Emilio Lozoya Austin solicitó a la Unidad de Inteligencia Financiera (UIF) que emita una respuesta pronta y oportuna 2023-04-14 15:38:00 |
 |

|
Xalapa.-
Inicia este lunes rehabilitación de Rébsamen y Circuito Presidentes |
| Se pavimentarán con concreto hidráulico más de 28 mil metros cuadrados, lo que equivale a casi tres campos de futbol profesional
2023-04-14 13:26:45 |
 |

|
Nacional.-
México y EU acuerdan sellar fronteras a fentanilo y mayor decomiso de armas |
| México se comprometió con Estados Unidos a duplicar las revisiones en puertos y a instalar más equipo en aduanas para evitar el ingreso de precursores de dr... 2023-04-14 12:27:54 |
 |

|
Nacional.-
Es promiscuidad política, AMLO critica alianza PAN-PRI en Coahuila |
| El presidente Andrés Manuel López Obrador criticó que hoy esos partidos políticos vayan como aliados. 2023-04-14 11:02:37 |
 |

|
Nacional.-
AMLO arremete contra INAI: ¿Para qué un aparato burocrático? No sirve para nada |
| El presidente Andrés Manuel López Obrador consideró que esta institución fue creada para simular que se combatía la corrupción. Criticó su alto costo al era... 2023-04-14 10:52:11 |
 |

|
Mundo.-
Lula llama a los países a abandonar el dólar y comerciar con monedas locales |
| En el marco de su visita a China, el presidente brasileño celebró las primeras transacciones entre ambas naciones intermediados por los yuanes en sustitució... 2023-04-14 10:44:08 |
 |

|
Nacional.-
Adiós a Notimex: propondrán iniciativa para liquidar a la agencia de noticias |
| Después de 3 años y dos meses de haber estallado la huelga en Notimex, el gobierno de AMLO habría decidido liquidar la agencia de noticias. 2023-04-14 10:17:22 |
 |

|
Nacional.-
Suman 3 funcionarios del INM detenidos por incendio en Ciudad Juárez |
| Sólo falta por ser detenido el delegado del INM, contraalmirante retirado, Salvador González Guerrero 2023-04-14 10:10:14 |
 |

